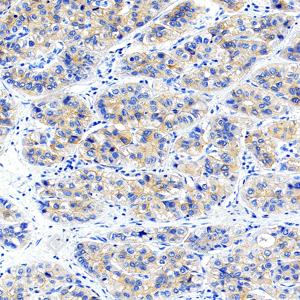

Recombinant Anti-EGFR antibody (Rabbit mAb)
- 50 μL
产品信息
蛋白质全称 | 表皮生长因子受体 |
别名 | EGFR, ERBB, ERBB1, HER1, NISBD2, PIG61, mENA, epidermal growth factor receptor, EGF receptor |
免疫原 | 人EGFR重组蛋白 |
Uniprot ID | P00533 |
抗体亚型 | IgG, κ |
克隆号 | SB358 |
纯化方式 | 亲和纯化 |
亚细胞定位 | 细胞质, 细胞核, 细胞膜, 分泌型 |
预测分子量. / 观测分子量. | 134 kDa / 175 kDa |
应用
| 应用 | 物种 | 稀释 | 阳性样品 |
| WB 免疫印迹 | 人, 小鼠, 大鼠 | 1: 1000-1: 4000 | 肝, HeLa细胞, A-431细胞 |
| IHC/IF 免疫组织化学/免疫荧光 | 人, 小鼠, 大鼠 | 1: 600-1: 1500 | 肾, 皮肤, 扁桃体 |
背景
The protein encoded by this gene is a transmembrane glycoprotein that is a member of the protein kinase superfamily. This protein is a receptor for members of the epidermal growth factor family. EGFR is a cell surface protein that binds to epidermal growth factor. Binding of the protein to a ligand induces receptor dimerization and tyrosine autophosphorylation and leads to cell proliferation. Mutations in this gene are associated with lung cancer.
图像
| WB检测EGFR蛋白(货号 GB151504). 样品: 经RIPA裂解液(货号G2002)处理的蛋白质. 封闭: 3%脱脂牛奶(货号GC310001)溶于TBST溶液, 室温孵育1小时. —抗: 1: 1000稀释, 4℃ 孵育过夜. 二抗: HRP标记山羊抗兔IgG (H+L) (货号GB23303), 1: 5000稀释, 室温孵育1小时. |
| WB检测EGFR蛋白(货号 GB151504). 样品: 经RIPA裂解液(货号G2002)处理的蛋白质. 封闭: 3%脱脂牛奶(货号GC310001)溶于TBST溶液, 室温孵育1小时. —抗: 1: 1000稀释, 4℃ 孵育过夜. 二抗: HRP标记山羊抗兔IgG (H+L) (货号GB23303), 1: 5000稀释, 室温孵育1小时. |
| IHC检测EGFR蛋白(货号 GB151504). 样品: 大鼠膀胱, 4%多聚甲醛 (货号G1101) 固定12-24小时. 抗原修复: 柠檬酸抗原修复液 (干粉, pH 6.0) (G1201), 高压锅均匀喷气计时2分钟. —抗: 1: 600稀释, 4℃ 孵育过夜. 二抗: S-vision免疫组化多聚二抗(山羊抗兔),即用型 (货号G1302), 室温孵育20分钟. |
| IHC检测EGFR蛋白(货号 GB151504). 样品: 人食管, 4%多聚甲醛 (货号G1101) 固定12-24小时. 抗原修复: 柠檬酸抗原修复液 (干粉, pH 6.0) (G1201), 高压锅均匀喷气计时2分钟. —抗: 1: 600稀释, 4℃ 孵育过夜. 二抗: S-vision免疫组化多聚二抗(山羊抗兔),即用型 (货号G1302), 室温孵育20分钟. |
| IHC检测EGFR蛋白(货号 GB151504). 样品: 人肝癌, 4%多聚甲醛 (货号G1101) 固定12-24小时. 抗原修复: 柠檬酸抗原修复液 (干粉, pH 6.0) (G1201), 高压锅均匀喷气计时2分钟. —抗: 1: 600稀释, 4℃ 孵育过夜. 二抗: S-vision免疫组化多聚二抗(山羊抗兔),即用型 (货号G1302), 室温孵育20分钟. |
| IHC检测EGFR蛋白(货号 GB151504). 样品: 人胎盘, 4%多聚甲醛 (货号G1101) 固定12-24小时. 抗原修复: 柠檬酸抗原修复液 (干粉, pH 6.0) (G1201), 高压锅均匀喷气计时2分钟. —抗: 1: 600稀释, 4℃ 孵育过夜. 二抗: S-vision免疫组化多聚二抗(山羊抗兔),即用型 (货号G1302), 室温孵育20分钟. |
| IHC检测 EGFR蛋白(货号 GB151504). 样品: 人扁桃体, 4%多聚甲醛 (货号G1101) 固定12-24小时. 抗原修复: 柠檬酸抗原修复液 (干粉, pH 6.0) (G1201), 高压锅均匀喷气计时2分钟. —抗: 1: 600稀释, 4℃ 孵育过夜. 二抗: S-vision免疫组化多聚二抗(山羊抗兔),即用型 (货号G1302), 室温孵育20分钟. |
| IHC检测 EGFR蛋白(货号 GB151504). 样品: 小鼠肾, 4%多聚甲醛 (货号G1101) 固定12-24小时. 抗原修复: 柠檬酸抗原修复液 (干粉, pH 6.0) (G1201), 高压锅均匀喷气计时2分钟. —抗: 1: 600稀释, 4℃ 孵育过夜. 二抗: S-vision免疫组化多聚二抗(山羊抗兔),即用型 (货号G1302), 室温孵育20分钟. |
| IHC检测 EGFR蛋白(货号 GB151504). 样品: 大鼠肝, 4%多聚甲醛 (货号G1101) 固定12-24小时. 抗原修复: 柠檬酸抗原修复液 (干粉, pH 6.0) (G1201), 高压锅均匀喷气计时2分钟. —抗: 1: 600稀释, 4℃ 孵育过夜. 二抗: S-vision免疫组化多聚二抗(山羊抗兔),即用型 (货号G1302), 室温孵育20分钟. |
| IHC检测 EGFR蛋白(货号 GB151504). 样品: 大鼠皮肤, 4%多聚甲醛 (货号G1101) 固定12-24小时. 抗原修复: 柠檬酸抗原修复液 (干粉, pH 6.0) (G1201), 高压锅均匀喷气计时2分钟. —抗: 1: 600稀释, 4℃ 孵育过夜. 二抗: S-vision免疫组化多聚二抗(山羊抗兔),即用型 (货号G1302), 室温孵育20分钟. |
| IF检测 EGFR蛋白(货号 GB151504)(红色). 样品: 小鼠皮肤, 4%多聚甲醛 (货号G1101) 固定12-24小时. 抗原修复: 柠檬酸抗原修复液 (干粉, pH 6.0) (G1201), 高压锅均匀喷气计时2分钟. —抗: 1: 600稀释, 4℃ 孵育过夜. 二抗: Cy3标记山羊抗兔IgG (H+L) (货号GB21303), 1: 300稀释, 室温孵育1小时. |
| IF检测EGFR蛋白(货号 GB151504)(红色). 样品: 大鼠皮肤, 4%多聚甲醛 (货号G1101) 固定12-24小时. 抗原修复: 柠檬酸抗原修复液 (干粉, pH 6.0) (G1201), 高压锅均匀喷气计时2分钟. —抗: 1: 600稀释, 4℃ 孵育过夜. 二抗: Cy3标记山羊抗兔IgG (H+L) (货号GB21303), 1: 300稀释, 室温孵育1小时. |
| IF检测EGFR蛋白(货号 GB151504)(红色). 样品: 人结肠癌, 4%多聚甲醛 (货号G1101) 固定12-24小时. 抗原修复: 柠檬酸抗原修复液 (干粉, pH 6.0) (G1201), 高压锅均匀喷气计时2分钟. —抗: 1: 600稀释, 4℃ 孵育过夜. 二抗: Cy3标记山羊抗兔IgG (H+L) (货号GB21303), 1: 300稀释, 室温孵育1小时. |
| IF检测EGFR蛋白(货号 GB151504)(红色). 样品: 人食管癌, 4%多聚甲醛 (货号G1101) 固定12-24小时. 抗原修复: 柠檬酸抗原修复液 (干粉, pH 6.0) (G1201), 高压锅均匀喷气计时2分钟. —抗: 1: 600稀释, 4℃ 孵育过夜. 二抗: Cy3标记山羊抗兔IgG (H+L) (货号GB21303), 1: 300稀释, 室温孵育1小时. |
| IF检测EGFR蛋白(货号 GB151504)(红色). 样品: 人肺癌, 4%多聚甲醛 (货号G1101) 固定12-24小时. 抗原修复: 柠檬酸抗原修复液 (干粉, pH 6.0) (G1201), 高压锅均匀喷气计时2分钟. —抗: 1: 600稀释, 4℃ 孵育过夜. 二抗: Cy3标记山羊抗兔IgG (H+L) (货号GB21303), 1: 300稀释, 室温孵育1小时. |
| IF检测EGFR蛋白(货号 GB151504)(红色). 样品: 人胎盘, 4%多聚甲醛 (货号G1101) 固定12-24小时. 抗原修复: 柠檬酸抗原修复液 (干粉, pH 6.0) (G1201), 高压锅均匀喷气计时2分钟. —抗: 1: 600稀释, 4℃ 孵育过夜. 二抗: Cy3标记山羊抗兔IgG (H+L) (货号GB21303), 1: 300稀释, 室温孵育1小时. |
| IF检测EGFR蛋白(货号 GB151504)(红色). 样品: 人扁桃体, 4%多聚甲醛 (货号G1101) 固定12-24小时. 抗原修复: 柠檬酸抗原修复液 (干粉, pH 6.0) (G1201), 高压锅均匀喷气计时2分钟. —抗: 1: 600稀释, 4℃ 孵育过夜. 二抗: Cy3标记山羊抗兔IgG (H+L) (货号GB21303), 1: 300稀释, 室温孵育1小时. |
| IF检测EGFR蛋白(货号 GB151504)(红色). 样品: 大鼠肝, 4%多聚甲醛 (货号G1101) 固定12-24小时. 抗原修复: 柠檬酸抗原修复液 (干粉, pH 6.0) (G1201), 高压锅均匀喷气计时2分钟. —抗: 1: 600稀释, 4℃ 孵育过夜. 二抗: Cy3标记山羊抗兔IgG (H+L) (货号GB21303), 1: 300稀释, 室温孵育1小时. |
储存
| 储存条件 | 在-20℃下储存一年, 避免反复冻融. |
| 储存缓冲液 | 含0.15% ProClin300防腐剂, 100 μg/mL牛血清白蛋白和50%甘油的磷酸盐缓冲液. |
注意:
1.本产品仅供研究使用.
2.建议用一抗稀释液(G2025)稀释本产品.
| 货号 | 名称 | 规格 | 价格 | 操作 |
|---|
| 货号 | 名称 | 规格 | 价格 | 操作 |
|---|